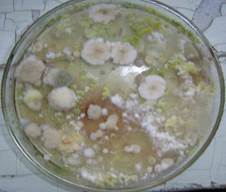
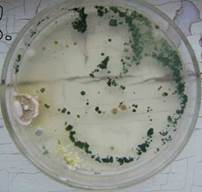

| Скачать .docx | Скачать .pdf |
Реферат: Биологическая активность гуминового комплекса различного происхождения и его влияние на рост и развитие
На правах рукописи
Юшкова Елена Ильинична
Биологическая активность гуминового комплекса различного происхождения и его влияние на рост и развитие растений
03.01.05 – физиология и биохимия растений
Автореферат
Диссертации на соискание ученой степени доктора биологических наук
Воронеж - 2010
Работа выполнена в ФГОУ ВПО "Орловском государственном аграрном университете", ГНУ ВНИИЗБК РАСХН.
Научный консультант:
доктор биологических наук, профессор Павловская Нинель Ефимовна
Официальные оппоненты:
доктор биологических наук, профессор Попов Василий Николаевич
доктор биологических наук, профессор Корнеева Ольга Сергеевна
доктор биологических наук, профессор Заякин Владимир Васильевич
Ведущая организация:
ГНУ Сибирский научно-исследовательский институт сельского хозяйства и торфа СО РАСХН
Защита диссертации состоится "2" ноября 2010 г. в 14 часов на заседании диссертационного совета Д 212.038.02 при Воронежском государственном университете по адресу: 394006, Россия, г. Воронеж, Университетская площадь – 1.
С диссертацией можно ознакомиться в Зональной научной библиотеке ГОУ ВПО "Воронежский государственный университет"
Автореферат разослан " " сентября 2010 г.
Ученый секретарь диссертационного совета Л.И. Брехова
Общая характеристика работы
Актуальность темы. Основной частью гумуса являются гумусовые кислоты (гуминовые кислоты, фульвокислоты, гиматомелановые кислоты). Гумусовые кислоты аккумуляторы органического вещества почвы – аминокислот, углеводов, пигментов, биологически активных веществ. Кроме того, в гумусовых кислотах концентрируются ценные неорганические компоненты – элементы минерального питания (азот, фосфор, калий), а также микроэлементы (железо, цинк, медь, марганец, бор, молибден и т.д.) (Кононова М.М., 1963; Александрова Л.Н., 1980; Орлов Д.С., 1990; Горовая А.И., Орлов Д.С., 1995). Многочисленными исследованиями установлено стимулирующее действие гуминовых веществ, особенно гуминовых кислот и их солей, на рост и развитие растений, повышение их устойчивости к неблагоприятным факторам окружающей среды, стимулирование прорастания семян, повышение продуктивности крупного рогатого скота и птицы.
Гуминовые кислоты, являясь составной частью объектов природного происхождения, находят самостоятельное применение в медицинской практике, фармации, косметологии. Создание оригинальных фармакотерапевтических препаратов с биостимулирующими и репаративными свойствами, средств для косметологии на основе гуминовых и гуминоподобных веществ, остается актуальным направлением исследований (Филов В.И., Беркович А.М., 2000; Солдаткина М.Н., 2006; Федько И.В., Гостищева М.В., Исматова Р.Р., 2005).
Особого внимания заслуживают адаптогенные свойства гуминовых веществ, обусловленные их способностью связывать радионуклиды, ионы тяжелых металлов, разрушать пестициды по истечении срока их действия, облегчать и ускорять процесс детоксикации культурных растений.
Спецификой гуминовых веществ является их вероятностный характер, обусловленный особенностями образования в результате естественного отбора устойчивых структур. Как следствие, к фундаментальным свойствам гуминовых веществ относятся нестехиометричность состава, нерегулярность строения, гетерогенность структурных элементов и полидисперсность. В связи с этим понятие молекулы для гуминовых веществ трансформируется в молекулярный ансамбль. Поэтому к ним не применим традиционных способ описания строения органических соединений, характеризующий количество атомов в молекуле, число и типы связей между ними.
Привлечение новейших физико-химических методов исследования гумусовых кислот, выделенных из различных природных объектов, дает возможность охарактеризовать их качественно и количественно. Полученные данные могут быть привлечены для объяснения строения и функций гумусовых кислот и, в связи с этим, механизмов их влияния на растительные и животные ткани, а также, причины изменения иммунного статуса организмов.
Исследования должны идти по пути поисков экологически безопасных биоактивных препаратов, способных влиять на фитоимунные процессы. Изучение механизмов формирования защитных и ростостимулирующих свойств у сельскохозяйственных растений под действием гуминовых препаратов позволит дать научное обоснование практического использования новых средств защиты. Однако, следует отметить, что ранее проведенные исследования осуществлялись в различных условиях и на образцах, полученных из различных природных объектов. Это в значительной степени осложняет сопоставление результатов и сравнение физико-химических свойств и физиолого-биохимической активности препаратов на основе гумусовых кислот (Алтунин Д.А., и др., 2000; Ищенко А.Ф., 2004; Кулик А.Ф., Горовая А.И., 1980; Шевелуха В.С., 1990).
Для получения гуминовых препаратов необходимо наличие биогумуса – первоисточника биологически активных веществ. Однако производство и практическое использование вермикомпостов осуществляется во многих случаях без достаточного научно-технического обеспечения, без надлежащего агрохимического и санитарно-гигиенического контроля. Кроме того, состав и физико-химические свойства гумусовых веществ имеют решающее значение для стандартизации различных видов вермикомпостов. Вместе с тем, до сих пор не разработан регламент получения вермикомпостов и критерии степени их зрелости.
Указанная ситуация определяет актуальность постановки систематических исследований по изучению состава, строения и свойств гуминовых веществ, входящих в состав биогумуса.
Цель исследования - изучить биологическую активность гуминового комплекса различного происхождения и выяснить разнообразные аспекты его действия на рост и развитие сельскохозяйственных растений.
В работе были поставлены следующие основные задачи:
- получить биогумус из разных видов компостов;
- исследовать вермикомпосты, полученные из разных субстратов, и определить интенсивность и механизмы гумификации;
- методами ВЭЖХ и сканирующей микроколориметрии провести анализ степени гумификации;
- используя гель-хроматографические методы, определить молекулярные массы белков биогумуса и жирнокислотный состав в исследованных препаратах;
- адаптировать существующие или разработать новые методики анализа для получения достоверных данных о составе, физико-химических и биологических характеристиках вермикомпостов;
- выделить и фракционировать гумусовые кислоты, исследовать их физико-химические свойства;
- провести сравнительное исследование гумусовых кислот, полученных из вермикомпостов различного происхождения;
- исследовать препараты гуминового комплекса разного срока созревания с помощью метода C13 ЯМР спектроскопии для идентификации и количественного определения функциональных групп и молекулярных фрагментов;
- выделить биологически активные вещества вермикомпоста и испытать их действие на устойчивость к биоте и хозяйственно-ценные показатели сельскохозяйственных культур;
- в полевых и лабораторных условиях выявить биологическую активность и сортоспецифичность препарата гуминового комплекса для разработки биологически активных фитоиммуномодуляторов.
Работа является комплексным исследованием, посвященным разработке методологии анализа органических объектов нерегулярного строения и анализу полученной информации, позволяющей прогнозировать их свойства.
Установлено влияние сроков созревания и природы субстрата для оценки агрономических, физико-химических и физиолого-биохимических характеристик вермикомпостов.
Разработаны методики выделения гумусовых кислот и их фракционирования. Впервые разработана и применена оптимизированная одноступенчатая методика извлечения гумусовых кислот, позволившая значительно сократить время экстракции.
Для хроматографической характеристики фульвокислот впервые разработан и применен метод ВЭЖХ в обращенных фазах.
Для исследования термодинамических характеристик комплекса гумусовых веществ и гуминовых кислот разработан и применен метод дифференциальной сканирующей микрокалориметрии.
Исследована антиоксидантная система гороха при обработке препаратом гуминового комплекса. Усовершенствована тест диагностика иммунизирующих и стимулирующих свойств биологически активных веществ.
Исследована возможность использования препарата гуминового комплекса для индуцирования устойчивости сельскохозяйственных растений к болезням и вредителям и повышения продуктивности.
Практическая значимость работы.
Получены разносторонние характеристики вермикомпостов, на основе различных субстратов, которые могут быть использованы с целью оценки степени завершенности процесса гумификации.
Данные, полученные при изучении химического, микробиологического состава и ферментативной активности вермикомпостов существенно дополняют представления о закономерностях трансформации органического вещества при участии вермикультуры.
Результаты исследований видового состава микробиологических сообществ вермикомпостов могут быть использованы для разработки рекомендаций санитарно-микологического контроля соответствующих производств.
Разработан комплекс методик анализа гумусовых кислот, включающий в себя: определение элементарного состава в расчете на безводную беззольную пробу; условия получения количественных 13 С ЯМР спектров; гель-хроматографическое определение молекулярных масс. Комплекс данных методик может быть внедрен в практику лабораторий химико-аналитического профиля.
Выделен гуминовый комплекс, обладающий иммунокорректирующим действием на растения, на основе которого возможно создание новых эффективных экологически безопасных средств защиты растений.
Существенный практический выход имеют данные о механизме фитогормонального действия гуминового комплекса, позволяющие диагностировать комплексную устойчивость сортообразцов к патогенам. Метод биотестирования (применения тест-систем) может служить в качестве метки в иммуноферментном анализе и предшествовать испытанию препаратов в полевых условиях.
Представлены рекомендации и разработан регламент применения гуминового комплекса при культивировании сельскохозяйственных культур.
Материалы исследования используются в учебном процессе кафедры общей, биологической, фармацевтической химии и фармакогнозии МИ ОГУ и кафедр физиологии и биохимии растений, биотехнологии и кормопроизводства ОГАУ при чтении курсов "Биотехнология", "Экология и охрана природы", "Физиология растений"; при выполнении дипломных проектов и кандидатских диссертационных работ.
Апробация работы. Основные положения диссертационной работы были представлены на Международной научно-практической конференции "Экология и жизнь" (Пенза, 2004), Втором съезде Общества биотехнологов России (Москва, 2004), Международной научной конференции "Фундаментальные и прикладные проблемы современной химии в исследованиях молодых ученых" (Астрахань, 2006), Межрегиональной научно-практической конференции с международным участием "Актуальные проблемы химии и методики ее преподавания" (Нижний Новгород, 2006, 2009), VI, VII Всероссийской конференции по анализу объектов окружающей среды "Экоаналитика – 2006" (Самара, 2006) "Экоаналитика – 2009" (Йошкар-Ола, 2009), II Всероссийской конференции по аналитической химии с международным участием (к юбилею академика Ю.А. Золотова) (Краснодар, 2007), Всероссийском симпозиуме "Хроматография в химическом анализе и физико-химических исследованиях" (к юбилею профессора О.Г. Ларионова) (Москва, 2007), Всероссийской научно-практической конференции "Инновационные технологии обеспечения безопасности питания и окружающей среды" (Оренбург, 2007), I, II Международной научно-практической конференции "Вермикультивирование и вермикомпостирование как основа экологического земледелия в XXI веке: проблемы, перспективы достижения" (Минск, Белоруссия, 2007, 2010), 55, 56 Всероссийской научно-практической конференции химиков с международным участием "Актуальные проблемы модернизации химического и естественнонаучного образования" (С-Петербург, 2008, 2009), Всероссийской научно-практической конференции "Биотехнология. Биомедицинская инженерная и технология современных социальных практик" (Курск, 2009).
Публикации. По материалам диссертации опубликовано 35 работ, в том числе коллективная монография.
Декларация личного участия автора. Вклад автора в работы, выполненные в соавторстве и включенные в диссертацию, состоял в формировании направления, активном участии во всех этапах исследования, постановке конкретных задач и их экспериментальном решении, интерпретации и обсуждении экспериментальных данных.
Положения, выносимые на защиту:
1. Предложенная методология анализа гумусовых кислот методами ВЭЖХ и сканирующей микрокалориметрии позволяют контролировать процесс гумификации.
2. Существуют корреляционные зависимости между структурно-групповым, молекулярно-массовым составом гумусовых кислот и источником происхождения (субстратом), периодом, а также временем вермикомпостирования, подтверждающиеся методами элементарного анализа, спектроскопии ЯМР на ядрах 13 С, эксклюзионной хроматографии.
3. Химическая структура и биохимические эффекты могут различаться в зависимости от способов извлечения, очистки и фракционирования препаратов; прогнозирование особенностей их свойств по общим элементам структуры возможно путем экспериментального анализа.
4. Природные компоненты препарата гуминового комплекса обладают иммуномоделирующими свойствами и могут служить основой для создания новых средств защиты растений.
5. Ферменты антиоксидантной системы клеток: супероксиддисмутаза, каталаза и пероксидаза являются диагностическим тестом на выявление биологической активности и подбор эффективных концентраций препаратов.
6. Полученный препарат гуминового комплекса усиливает пероксидазозависимый иммунитет и повышает продуктивность сельскохозяйственных культур.
Структура и объем работы. Диссертационная работа изложена на 356 страницах машинописного текста, содержит 121 рисунок, 39 таблиц и состоит из введения, 6 глав, заключения, основных выводов и списка литературы, приложения. Список цитируемой литературы включает 430 наименований, из которых 150 зарубежные.
Настоящая работа представляет собой часть плановых научно-исследовательских работ Орловского государственного университета, Орловского государственного аграрного университета. Исследования проводились также в сотрудничестве с Всероссийским научно- исследовательским институтом зернобобовых и крупяных культур РАСХН в рамках программы ГНЦ "Разработка методов повышения иммунных свойств, диагностики и интегрированных систем защиты зернобобовых и крупяных культур от болезней и вредителей"; институтом биохимической физики им. Н.М. Эммануэля РАН.
Содержание работы
Во введении обосновывается актуальность исследования, его практическая и теоретическая значимость; сформулированы цель и основные задачи работы; намечены пути их реализации.
1. Общая характеристика и методы исследования гуминовых веществ различных природных объектов (литературный обзор)
В главе представлен свод основных работ, посвященных общей характеристике биогумуса и гуминовых веществ; рассмотрению состава, функций гуминовых веществ в почвенных экосистемах; физиолого-биохимической характеристике и применению их в медицине. Поскольку основной составной частью гуминовых веществ являются гумусовые кислоты, то особое внимание уделено способам выделения, исследованию состава и свойств гумусовых кислот. Анализ литературных данных дает возможность охарактеризовать качественно и количественно с использованием новейших физико-химических методов исследования гумусовые кислоты, выделенные из различных природных объектов.
2. Методики получения препаратов биогумуса и гумусовых кислот. Объекты и методы исследования
Биогумус как основа для получения биологически активных веществ произведен в результате жизнедеятельности элитной промышленной линии дождевых (компостных) червей Владимирский гибрид "Старатель". Выращивали червей на различных субстратах (компосты: конский, свиной, птичий; осадок сточных вод). Для исследований получены образцы биогумуса разного периода созревания: с января по апрель – "зимний"- образец, с апреля по октябрь – "летний" - образец; разного срока созревания (1,5 месяца компостирования, 3 месяца, 6 месяцев).
Агрохимические и микробиологические характеристики биогумуса проводили по следующим методикам: определение фосфора и калия по Кирсанову в модификации ЦИНАО, количество аммиачного и нитратного азота в почве методом Корнфильда (Радов А.С. и др., 1985); содержание золы, концентрацию водородных ионов в субстратах и биогумусе по Петербургскому А.В. (1968); аммонифицирующую активность и содержание нитратов по Радову А.С. (1985). Чистые культуры микроорганизмов выращивали на среде Чапека. Целлюлозоразрушающую активность определяли модифицированным методом Кристенсена (Ежов Г.И., 1981).
Водные экстракты биогумуса получали добавлением к 20 г сухих образцов вермикомпостов и контрольного образца (компоста) 100 мл 50 мМ фосфатного буфера (рН 7,6). Экстракцию проводили при перемешивании магнитной мешалкой и комнатной температуре. Полученные суспензии центрифугировали в течение 30 мин при 10000 об/мин (центрифуга – Т-24 , MLШ Германия). В супернатантах определяли содержание растворимых веществ.
Спиртовые экстракты получали так же как описано выше, для водной экстракции. Содержание экстрагированных веществ определяли методом высушивания до постоянного веса.
Протеолитическую активность экстрактов исследовали по отношению к гемоглобину, растворенному в 50 мМ фосфатном буфере (рН 7,6). Оптическую плотность супернатантов инкубируемой смеси измеряли спектрофотометрически.
Амилолитическую активность экстрактов исследовали по отношению к 1% суспензии картофельного крахмала в 50 мМ фосфатном буфере с рН 7,6. Методика основана на определении содержания редуцирующих групп путем окисления карбонильной группы моно-, ди-, олиго- и полисахаридов до карбоксильной 3,5 - динитросалициловой кислотой, что приводит к переходу окраски от желтой к красно-бурой.
Выделение гуминовых кислот и фульвокислот. Навески образцов для удаления солей и карбоксигидратов обрабатывали 0,1N раствором HCl, затем перемешивали на магнитной мешалке и центрифугировали. Из полученных осадков методом щелочной экстракции извлекали гуминовые кислоты и фульвокислоты. Процедура экстракции была проведена 11 раз. Полнота экстракции контролировалась метода ВЭЖХ.
Выделение гиматомелановых кислот. Взвешенные препараты гуминовых кислот помещали в виалы и растворяли в минимальном объеме 1N раствора NaOH при перемешивании магнитной мешалкой. После полного растворения проводили спиртовую экстракцию (метанол, этанол и пропанол) в течение 12 часов под аргоном. Полученные суспензии центрифугировали, супернатанты помещали в виалы. Концентрацию ГМК в растворе определяли методом высушивания до постоянного веса за вычетом сухого веса высушенного растворителя (спирт с 0,1 N раствор NaOH). При исследованиях методом ВЭЖХ использовали растворы ГМК с концентрацией 1 мг/мл.
Все используемые реактивы имели марку "х.ч." и "ч.д.а.".
Хроматографические исследования гуминовых кислот проводили на хроматографе "Gilson", оснащенным компьютером с программой приема и обработки хроматографических данных. Сбор и обработка хроматографических данных осуществляется через программу Мультихром или Gilson Unipoint. Измерения проводили в изократическом, градиентном и обращеннофазовом режимах. Детектирование хроматографических пиков осуществлялось УФ-детектором при 220 и 280 нм. Для хроматографирования использовали следующие колонки: Alltima C8 (250x4,6 мм; 5 мкм); Macrosphere RP 300 C8 (250x4,6 мм; 5 мкм); Platinum EPS C18 (250x4,6 мм; 5 мкм). Все используемые реактивы имели марку "Для ВЭЖХ".
Исследование экстрактов биогумуса проводили методом гель-фильтрации на геле сефадекс G-75 с непрерывной автоматической регистрацией оптической плотности элюата в проточной кварцевой кювете, колонка TSK G4000SW (8x300 мм). Объем аликвоты раствора 100 мкл, скорость элюирования 0,4 мл/мин. В качестве элюента использовали 50 мМ фосфатный буфер с рН 7,6. Детектирование пиков хроматограмм осуществляли при 254 нм.
Определение жирнокислотного состава компостов и вермикомпостов проводилось методом газожидкостной хроматографии на хроматографе "Agilent 6890N", оснащенном масс-спектрометрическим детектором "Agilent 5973N" и капиллярной колонкой HP – 5MS 0,25mm×30m×0,25mm. Идентификацию жирных кислот проводили с помощью компьютерного поиска (РВМ) и библиотеки масс-спектров Wiley.
Спектроскопические измерения проводили на спектрофотометре Specord UV/VIS (Carl Zeiss, Jena, Германия). Specord сканирующий UV/VIS спектрофотометр, работающий как автономное устройство со встроенным микропроцессором и в системе с внешним компьютером. Диапазон длин волн 190 - 1100 нм, соответствует требованиям стандарта DAB.
Для спектрофотометрического анализа использовали фотометр фотоэлектрический КФК-3-01.
Спектры ЯМР регистрировались на твердофазном ЯМР-спектрометре Bruker DSX 200 при резонансной частоте 50,3 МГц, с использованием cross-поляризации, magic angle spinning техники c spinning speed 6,8 кГц. Контактное время 1 мсек, pulse delay 400 мсек.
Микроколориметрические исследования гумусовых кислот проводили на адиабатном сканирующем микроколориметре ДАСМ-4А (институт биологического приборостроения РАН, г. Пущино Московской области, Россия) с объемом рабочей ячейки 0,4672 см3 . В каждом эксперименте шкалу теплоемкости калибровали по эффекту Джоуля-Ленца. Диапазон сканирования температур от 20 до 120ºС, скорость нагрева - 2ºС/мин. Концентрация ГВ в растворах составляла 8 мг/мл в 0,1 М фосфатном буфере, содержащем 0,4 М хло рид натрия с рН 7,7, гуминовых кислот – 6 мг/мл.
Извлечение биологически активных веществ из биогумуса и компоста (контроль) проводили методом экстракции. Выход активного вещества составлял 3,25 мг на 1 кг биогумуса. Приготовленный препарат гуминового комплекса считали как раствор 1:1. Далее готовили испытуемые растворы разведением дистиллированной водой до концентраций 1,5·10-2 , 1,5·10-3 , 1,5·10-4 %.
Для определения каталазы в растениях была использована методика А.И. Ермакова с модификациями (1987).
При определении пероксидазной активности растений использовали колориметрический метод Бояркина А.Н. с модификациями (1981). Метод основан на определении скорости реакции окисления бензидина до образования синего продукта окисления определенной концентрации, заранее устанавливаемой на фотоэлектроколориметре. Измерение проводили с использованием красного светофильтра при длине волны λ =590 нм.
Для определения активности супероксиддисмутазы (СОД) применялась модифицированная методика с использованием фотореактора (GiannopolitiesC.N., Ries S.K., 1977; Гринблат А.И., 2007).
Для лабораторных исследований биологической активности гуминового комплекса использовали сорта гороха, обладающие ценными хозяйственными признаками, но разной степенью восприимчивости к болезням и вредителям: горох "Норд" на зерно (ГНУ ВНИИЗБК, 1992), горох "Орпела" (ГНУ ВНИИЗБК, 1994).
Для полевых исследований влияния растворов гуминового комплекса на поражаемость болезнями и вредителями, продуктивность и урожайность использовался следующие сорта сельскохозяйственных растений: горох "Вега" - овощной сорт (ГНУ ВНИИ селекции овощных культур, 1982), горох "Батрак" (ГНУ ВНИИЗБК, 2000), картофель "Жуковский ранний" (селекция ВНИИ КХ), пшеницу сорт "Крестьянка".
Обработку семян (клубней) проводили путем замачивания в течение 2 часов в растворах гуминового комплекса с концентрациями 1,5·10-2 , 1,5·10-3 , 1,5·10-4 %, вытяжке из компоста с концентрацией 1,5·10-2 % и растворе "Гумистар", приготовленного промышленным способом (производство ОАО МНПК "ПИКЪ"), с концентрацией 1,5·10-2 %. В качестве контроля использовали замачивание семян в растворе дистиллированной воды.
Для лабораторных опытов семена перед использованием обеззараживали 1 % - ным раствором дезолона. Исследовали 7 вариантов. В 3-х вариантах использовали предпосевную обработку семян (клубней) испытуемыми растворами, и в 3-х сочетали обработку семян с 2-х разовым опрыскиванием растений. Площадь делянки составляла 10 м2 (для гороха и пшеницы), 2 м2 (для картофеля) повторность 4 - кратная. Учёт распространения и развития болезней проводили по методикам Н.Н. Кирика и В.В. Котовой (1979), В.И. Попова, М.Ю. Степановой (1981). Поражённость корневой системы гнилями определяли по 4-х бальной шкале, поражение пятнистостями по 5-ти бальной в фазу бутонизации и цветения (период массового заселения растений вредителями) и в фазу плодообразования (во время массовой откладки яиц) (Котова В.В., 1986).
Опытный материал выращивали в условиях полевого опыта на делянках площадью 10 м2 в 4-х кратной повторности при норме высева 1,2 млн. шт./га размещение делянок риндомизированное. Посадку картофеля производили по схеме: 0,3х0,7 м, густота стояния растений составляла 47619 шт. растений/га.
Обработку семян исследуемыми растворами проводили за 1-2 дня до посева гороха суспензионным способом, вручную. Обработку посевов проводили дважды в период бутонизации и цветения. Анализ семян, обработанных препаратами на всхожесть, заражённость проводили на 4-й, 7-й день после обработки согласно методикам (Методические указания по государственному испытанию фунгицидов, антибиотиков и протравителей семян сельскохозяйственных культур, 1985). По сноповому материалу определяли структуру урожая (количество бобов и семян на одном растении и масса 1000 семян) (Методика Госсортсети, 1981).
Обработку экспериментальных данных проводили методом Б.А. Доспехова с помощью компьютерной программы Ехеl (1985).
3. Исследование состава водных и спиртовых экстрактов вермикомпостов
Для сравнительного исследования физико-химических свойств и ферментативной активности экстрактов вермикомпостов был получен биогумус различного периода созревания.
Анализ биогумуса показал, что его химические свойства зависят от времени культивирования (табл. 1).
Вермикомпостирование приводит к повышению рН-среды, рН приближается к нейтральной; общий азот увеличивается.
Содержание обменного калия К2 О незначительно снижается, а содержание Р2 О5 увеличивается по мере биокомпостирования и находится в пределах величин мирового стандарта. Содержание золы, напротив, значительно возрастает (на 10 - 15%), что обогащает почву необходимыми макро- и микроэлементами. Ключевым показателем при оценке скорости биоконверсии органических отходов и степени зрелости вермикомпостов, по данным международного стандарта, является соотношение С/N. По нашим данным, этот показатель снижается при биокомпостировании, что указывает на его зрелость.
Таблица 1 Агрохимический состав биогумуса различного периода созревания
| Вид удобрения |
Гумус, % |
рН |
Азот общий, % |
Зола,% |
Р2 О5 , % |
К2 О, % |
С/N |
| Компост |
17,3 |
5,8 |
2,81 |
57,1 |
1,20 |
0,70 |
22,1 |
| Биогумус (зимний) |
17,8 |
6,3 |
1,71 |
73,2 |
0,78 |
0,71 |
13,7 |
| Биогумус (летний) |
26,2 |
6,3 |
2,25 |
65,6 |
1,13 |
0,66 |
17,7 |
| Международный стандарт |
20-30 |
6,5-7,5 |
1,0 |
57,7 |
1,5 |
1,0 |
- |
Анализ микробиологических свойств вермикомпоста показал, что это – продукт с достаточно стабильным микробным сообществом. При естественной влажности (около 74%) он характеризуется определенной пропорцией микробной биомассы: 63-71% - грибной мицелий; 21-28% - споры грибов и дрожжеподобные организмы; 5,6-6,7% - бактерии; 2,3-3,2% - мицелий актиномицетов. В отличие от исходного субстрата в вермикомпосте снижается доля грибного мицелия, но возрастает доля функционально-активного мицелия актиномицетов; в группе бактерий доминируют представители актиномицетной линии; среди грибов преобладают активные целлюлозоразрушающие виды, которые не токсичны и не патогенны для растений, а напротив, обладают антагонистическим эффектом по отношению к фитопатогенным микроорганизмам.
Исследование почвенной микрофлоры образцов биогумуса показало (табл. 2), что аммонифицирующая активность значительно повышается по сравнению с компостом в 2,6 и 1,8 раз соответственно, а нитрифицирующая активность снижается (от 19,2 мг в компосте до 17,8 и 17,6 – в биогумусе).
Таблица 2 Аммонифицирующая и нитрифицирующая активность биогумуса
| Образец |
Аммонифицирующая активность N-NH4 + мг/100г образца (при компостировании с люпиновой мукой) |
Нитрифицирующая активность N-NО3 - мг/100г образца (при компостировании с сульфатом аммония) |
| Компост |
5,6 |
19,2 |
| Биогумус, зимний |
14,5 |
17,8 |
| Биогумус, летний |
10,0 |
17,6 |
Установлено, что все образцы обладают высокой целлюлозоразрушающей активностью, что положительно сказывается на закреплении азота в органической биомассе целлюлозорарушающих микроорганизмов.
Исследование по выделению и идентификации грибковых сообществ в компосте и вермикомпосте показали, что в компосте доминируют грибы родов Mucor, Fusarium, Penicilium и Trichoderma. Общее количество почвенных грибов составляло до 60 тыс/г образца, количество колоний рода Fusarium составляло 9 - 11 тыс/г образца, что составляет 15 - 18% от общего количества (рис. 1 (а)).
а)
а)
![]() б)
б)
в)
в)
Рисунок 1. Состав грибной микрофлоры в компосте (а), биогумусе зимнем (б), биогумусе летнем (в)
По мере компостирования биогумуса доминирующее положение занимают грибы pода Trichoderma, вытесняя другие виды, в том числе и представителей патогенного рода Fusarium (рис. 1 (б, в)). В последнем образце насчитывалось 3 - 5 тыс/г образца представителей сапрофитной микрофлоры – грибов рода Penicilium, остальное приходилось на колонии pода Trichoderma. Биогумус по мере созревания обогащается грибами - антагонистами (Trichoderma) и тем самым приобретает свойства оздоравливающего действия.
Знание микробиологических свойств и их связи с полезными и вредными свойствами вермикомпоста необходимы для контроля производства и получения высококачественных продуктов. Методы, основанные на определении видового состава сообщества компоста, эффективны для выявления фитопатогенной микрофлоры и санитарных микроорганизмов. Характеристики такого типа необходимы для определения гигиенических качеств вермикомпостов. Кроме того, изменение функциональной структуры микробиологических сообществ может быть приемлемым для определения степени зрелости вермикомпостов.
Экстракцию водорастворимых веществ компостов и вермикомпостов проводили 0,1 М фосфатным буфером при рН = 7,6. Показано (рис. 2) , что из субстрата, не обработанного червями максимально экстрагируется 4 мг/мл вещества, в то время как из образца, полученного с января по апрель (зимний), экстрагируется 1,6 мг/мл, а из образца, полученного в период с апреля по октябрь (летний) – 1,2 мг/мл.
 а)
а)
 б)
б)
Рисунок 2. Динамика экстрагируемости водорастворимых веществ (экстракция 0,1 M фосфатным буфером; pH 7,6) - а) из компоста; б) из вермикомпоста: 1 - зимний образец вермикомпоста, 2 - летний образец вермикомпоста.
Из выше приведенных данных следует, что не менее половины (4/1,6 = 2,5; 4/1,2 = 3,5) водорастворимых веществ после обработки образцов червями, по-видимому, гумифицируется. Следует также отметить, что оставшиеся после обработки компоста червями органические вещества быстрее вымываются водой (3 ч), в сравнении с контролем (16 ч). Экстракты компоста и вермикомпостов были исследованы методом гель-хроматографии. При существующей неопределенности структуры ГВ возможность создания универсальных ММ стандартов на сегодняшний день практически исключена. В этой ситуации представляется целесообразным оценить эффективность гель-хроматограммы приняв во внимание распределение в хроматографическом профиле отдельных фракций, различающихся по физико-химическим свойствам. Площади, занимаемые максимумами, пропорциональны количественному содержанию фракций. На рисунках 3(а) и 3(б) приведены гель – хроматограммы для экстрактов зимнего и летнего образцов вермикомпостов. Хроматограммы содержат по одному пику с одинаковым временем удерживания на колонке, что свидетельствует о близких молекулярных массах веществ, содержащихся в образцах. Асимметрия пиков указывает на присутствие двух или нескольких веществ с близкой молекулярной массой.
 а)
а)
 б)
б)
Рисунок 3. Гель - хроматограмма водного экстракта биогумуса: а) образец - зимний, б) образец – летний; детектирование-254 нм.
На рисунке 4 приведена гель - хроматограмма для образца компоста, не обработанного червями – контроль.
 Время
Время
Рисунок 4. Гель - хроматограмма водного экстракта компоста контрольного образца, детектирование – 254 нм.
Приведенная хроматограмма содержит, помимо основного пика, дополнительный пик-1, соответствующий большей молекулярной массе вещества. Этот факт говорит о том, что возможна ассоциация молекул гумусовых кислот и образование в растворе статических клубков. При различных значениях рН конформация молекул может изменяться вследствие электростатического отталкивания ионизированных карбоксильных групп, приводя к увеличению линейных размеров молекул.
Увеличение доли высокомолекулярной фракции в экстрактах вермикомпостов объясняется, вероятно, тем, что при участии червей меняется природа гумусового вещества, происходит обогащение новообразованными гуминовыми кислотами, возникающими за счет преобразования растительных остатков. Кроме того, усиливается микробиологическая активность, что в свою очередь приводит к усилению процессов гумификации и образованию более зрелых биотермодинамически устойчивых ГК, имеющих большую молекулярную массу и обеспечивающих повышение плодородия почв.
Методом гель-фильтрации определены молекулярные массы белков биогумуса. Молекулярная масса белка из биогумуса вычислена по нижеследующему уравнению:
Y = - 0,3829х + 2,083 исходя из К = 0,65 для белка из биогумуса. Она равна »27 кДа.
Для определения жирных кислот в препаратах экстрактов биогумуса и компоста использовали метод газожидкостной хроматографии с масс-спектрометрическим детектором. В таблице 3 приведены данные жирнокислотного состава в исследованных препаратах.
Таблица 3 Содержание жирных кислот в биогумусе
| № п./п. |
Название вещества |
летний |
зимний |
контроль |
| Содержание в гумусе, нг/г |
||||
| 1 |
Октадекановая |
500 |
370 |
200 |
| 2 |
Метилэйказоновая |
15 |
10 |
5 |
| 3 |
Доказоновая |
300 |
250 |
150 |
| 4 |
Метилдоказоновая |
20 |
15 |
5 |
| 5 |
Триказоновая |
10 |
5 |
- |
| 6 |
Тетраказоновая |
150 |
100 |
50 |
| 7 |
Пентаказоновая |
5 |
5 |
- |
| 8 |
Гексаказоновая |
20 |
15 |
5 |
| 9 |
Гептаказоновая |
5 |
- |
- |
| 10 |
Метилгептадекановая |
120 |
90 |
40 |
| 11 |
Октодеценовая |
500 |
400 |
200 |
| 12 |
Гептадекановая |
120 |
100 |
100 |
| 13 |
Гексадекановая |
400 |
320 |
270 |
| 14 |
Пентадекановая |
200 |
170 |
120 |
Содержание жирных кислот в контрольном образце и образцах, обработанных червями, неодинаково. Содержание жирных кислот в препаратах летнего образца выше, чем в зимнем образце, а в препарате, не обработанном червями (контроль) оно наиболее низкое. Из литературы известно, что с ростом гумификации содержание жирных кислот действительно возрастает.
Протеолитическую активность экстрактов биогумуса и компоста исследовали по отношению к 1%-ого раствору гемоглобина. Оптическую плотность супернатантов инкубируемой смеси гемоглобина и экстрактов биогумуса измеряли в 10 мм кварцевых кюветах при 280 нм против 10% раствора ТХУ в фосфатном буфере. Измерения проводили на спектрофотометре Specord UV/VIS(Carl Zeiss,Jena, Германия). Результаты анализа приведены на рисунке 5.
Кинетика протеализа
 а)
а)
 б)
б)
Рисунок 5. Зависимость изменения оптической плотности растворов ТХУ (10%) растворимой фракции 1% раствора гемоглобина от времени инкубирования с водными растворами экстрактов а) компоста, б) биогумуса: 1 – зимний образец, 2 – летний образец.
Определено, что препарат биогумуса зимний (1) обладает более высокой протеолитической активностью, чем препарат летний (2) (рис. 5 (б)). Кинетические кривые имеют типичную форму для кинетики ферментативных гидролитических процессов.
Результаты анализа образца компоста, не обработанного червями, приведены на рисунке 5 (а). Видно, что контрольный образец не обладает протеолитической активностью, в отличие от зимнего и летнего образцов.
При исследовании амилолитической активности экстрактов вермикомпостов и компоста по отношению картофельному крахмалу (50 мМ фосфатный буфер, рН 7,6) в течение 24 часов ее обнаружить не удалось. Возрастания оптической плотности от времени инкубирования получено не было. Отсутствие амилолитической активности, возможно, связано с низким количеством амилаз в вермикомпосте и компосте.
4. Выделение и сравнительное исследование физико-химических свойств гумусовых кислот методами ВЭЖХ и спектрофотометрии
Углубленное изучение свойств и природы гумусовых веществ возможно с применением современных физико-химических методов исследования. Они позволяют раскрыть генетические особенности гумусовых веществ, развивающихся в разных условиях.
Гуминовые кислоты являются основным гумусовым компонентом. Они не растворимы в кислоте и спирте, у них средний молекулярный вес и темная окраска. Извлеченные методом экстракции из вермикомпостов разного периода созревания гуминовые кислоты были исследованы методами спектрофотометрии и ВЭЖХ. На основании УФ-спектров установлено наличие в гуминовых кислотах ароматических групп. Отношение оптической плотности при 280 нм к оптической плотности при 220 нм – D280 /D220 , характеризует относительное содержание ароматических групп в гуминовых кислотах. Данные спектрофотометрии не показали значительного изменения относительной ароматичности в образцах компоста и вермикомпостов (гуминовые кислоты компоста - D280 /D220 =0,47; гуминовые кислоты вермикомпостов D280 /D220 =0,45). Однако следует учесть, что при спектрометрическом исследовании гуминовые кислоты в растворе находятся в агрегированном состоянии, при хроматографии эти агрегаты разрушаются, поэтому данные хроматографического исследования являются более объективными.
Методом ВЭЖХ экстракты гуминовых кислот разделены на три фракции. Фракции 1 и 2 являются гидрофильными, фракция 3 содержат гидрофобные функциональные группы, в основном ароматического ряда, причем содержание этой фракции возрастает приблизительно в 3 раза для гуминовых кислот, выделенных из летнего образца вермикомпоста по сравнению с контролем, т. е. степень гумификации летнего образца более высокая.
Вероятно, одной из причин физиологической активности гуминовых кислот является наличие в их молекулах фрагментов, обладающих свойствами стабильных свободных радикалов, а их содержание, по-видимому, увеличивается с ростом степени гумификации субстратов.
Фульвокислоты являются водорастворимой частью гуминовых веществ и представляют собой высокомолекулярные азотсодержащие оксикарбоновые кислоты с эквивалентным весом около 300 а.е.м. (Ищенко А.В., 1999). От гуминовых кислот они отличаются более низкой молекулярной массой, более низким содержанием углерода, светлой окраской. Фульвокислоты растворяются в воде щелочных и кислых растворах, обладают склонностью к кислотному гидролизу.
Наибольшее количество фульвокислот проэкстрагировано из образца, не обработанного червями (контроль). Всего проэкстрагировано фульвокислот: из компоста (контроль) - 980 мг; из образца - зимний – 590 мг; образца - летний – 660 мг.
Анализ хроматографических данных экстрактов вермикомпостов (летний и зимний) выявил наличие 4 фракций фульвокислот. Фракции 1 и 2 сходны по составу, содержат более 70% вещества и, вероятно, наиболее богаты гидрофильными компонентами, этим объясняется лучшая растворимость фульвокислот при различных значениях рН. Содержание гидрофобных фракций 3 и 4 незначительно. Выделенные фракции экстрактов зимнего и летнего образцов вермикомпостов сходны по составу и одинаковому относительному содержанию в исследуемых образцах.
Хроматограмма контрольного образца существенно отличается от выше описанных. На хроматограмме контроля проявляются два дополнительных пика, что указывает на более сложный компонентный состав данного образца. Это обстоятельство может быть связано с гидротермическими и микробиологическими особенностями формирования фульвокислот под действием вермикультуры и без нее.
Для хроматографической характеристики фульвокислот разработан и применен метод ВЭЖХ в обращенных фазах, поскольку в литературе отсутствуют данные о характеристике фульвокислот, исследованных методом ВЭЖХ в обращеннофазовом режиме. Для получения интегральной хроматографической характеристики фульвокислот из экстрактов 1-8 были отобраны аликвоты по 1 мл и объединены, для 3-х образцов (летний, зимний, контроль) в отдельности.
При проведении хроматографического разделения фульвокислот получили 3 фракции. В первых двух преобладали гидрофильные фрагменты, третья содержала гидрофобные радикалы. Сравнительный анализ хроматограмм для исследованных образцов показал, что, полученные фракции, аналогичны по составу и относительному содержанию компонентов. Установлено возрастание содержания алифатических углеводородов и карбоксильных групп, содержание ароматических колец и полисахаридных фрагментов в фульвокислотах уменьшается с ростом степени гумификации.
Поскольку фульвокислоты обогащены кислородсодержащими фрагментами, то они имеют лучшую растворимость в воде и миграционную способность. Высокое содержание карбоксильных групп (до 27,1%) обусловливает кислотную агрессивность ФК по отношению к почвенным минералам и способность образовывать комплексные соединения с катионами железа, алюминия, меди и других металлов, переводя их в растворимые формы.
Высокая подвижность ФК, высокая поглотительная способность позволяют считать их важнейшим фактором, определяющим почвенное плодородие.
Оптимизация выделения гумусовых кислот. Ранее использовалась стандартная процедура экстракции гумусовых кислот, рекомендуемая IHSS (Swift R.S., 1999)
Ее использование позволяло извлечь максимальное количество экстрагируемых веществ, однако эта методика включает 11 процедур экстракции по 24 часа для извлечения гумусовых кислот (гуминовые кислоты и фульвокислоты) и столько же процедур по 20 часов для разделения гуминовых и фульвокислот. Используя данные по полноте экстракции гуминовых кислот по ранее используемой методике, оптимизирован одноступенчатый метод выделения гумусовых кислот. В таблице 4 приведены данные по экстрагируемости гумусовых кислот. Из таблицы видно, что при соотношении 1/100 из образцов практически извлекается такое же количество гумусовых кислот как и при 11 экстракциях. На этом основании в дальнейших работах можно использовать для извлечения гумусовых кислот только одну экстракцию при соотношении биогумус (компост)/экстрагент (0,1 N NaOH; pH 12,5), время экстракции 24 часа.
Таблица 4 Экстрагируемость гумусовых кислот из компоста и биогумуса в зависимости от соотношения масса биогумуса (компоста)/ объем экстрагента
| Наименование образца |
Экстрагируемость гумусовых кислот, г (%) |
||
| Проведение 11 экстракций при соотношении 1/10 |
Проведение 1 экстракции при соотношении 1/50 |
Проведение 1 экстракции при соотношении 1/100 |
|
| контроль |
2,08 |
1,12 |
1,95 |
| зимний |
1,42 |
0,56 |
1,51 |
| летний |
1,56 |
0,86 |
1,49 |
Гиматомелановые кислоты — группа гумусовых кислот, растворимых в этаноле. Выделяются из свежеосажденной гуминовой кислоты раствором этилового спирта. В растворе имеют вишнёво-красный цвет.
Для сравнительного физико-химического анализа гиматомелановых кислот компостов и вермикомпостов их выделяли из сухих препаратов гумусовых кислот, полученных по выше приведенной оптимизированной методике.
В таблице 5 приведены данные по экстагируемости гиматомелановых кислот различными спиртами.
Таблица 5 Экстрагируемость гиматомелановых кислот различными спиртами
| Наименование образца |
Экстрагируемость спиртами, мг/г (%) |
||
| метанол |
этанол |
Пропанол |
|
| контроль |
155 (15,5) |
200 (20,0) |
75 (7,5) |
| зимний |
183 (18,3) |
215 (21,5) |
85 (8,5) |
| летний |
155 (15,5) |
233 (23,3) |
60 (6,0) |
Из таблицы 5 видно, что максимальное весовое количество гиматомелановых кислот экстрагируется этанолом (от 20 до 23%).
Хроматограммы для исследованных образцов гиматомелановых кислот существенно отличаются друг от друга, как количеством пиков, так и интенсивностью поглощения. Для сравнения хроматографических данных были использованы интегральные характеристики пиков, а именно суммарные площади под пиками хроматограмм.
В таблице 6 приведены хроматографические данные по суммарным площадям под пиками хроматограмм при детектировании 220 и 280 нм, а также данные по относительной ароматичности препаратов из 3-х исследованных образцов (контроль, зимний, летний).
Из таблицы 6 видно, что при экстракции метанолом и этанолом уменьшаются площади под пиками хроматограмм в следующем ряду: контроль > образец-зимний > образец-летний, как при детектировании 220 нм, так и - 280 нм, что свидетельствует об уменьшении содержания как карбоксильных и карбонильных групп, так и фенольных групп в гиматомелановых кислотах. В то же время, соотношение ∑S 280 /∑S 220 остается практически неизменным.
Последний факт свидетельствует о приблизительно одинаковой относительной ароматичности исследованных образцов гиматомелановых кислот, или другими словами, возрастание степени гумификации гуминовых кислот разного срока созревания не связано с изменением относительной степени ароматичности гиматомелановых кислот.
При экстракции пропанолом экстрагируемость гиматомелановых кислот приблизительно в 2- 3 раза ниже, чем при экстракции метанолом или этанолом (табл. 6).
Таблица 6 Хроматографические данные гиматомелановых кислот при экстракции различными спиртами
| Наименование образцов |
Используемые спирты |
||||||||
| метанол |
этанол |
Пропанол |
|||||||
| ∑S280 |
∑S 220 |
∑S 280 /∑S 220 |
∑S 280 |
D220 |
∑S 280 /∑S 220 |
∑S 280 |
∑S 220 |
∑S 280 /∑S 220 |
|
| контроль |
655 |
4674 |
0,14 |
863 |
5826 |
0,15 |
632 |
5880 |
0,11 |
| зимний |
150 |
917 |
0,16 |
328 |
3340 |
0,10 |
2235 |
2716 |
0,82 |
| летний |
135 |
895 |
0,15 |
296 |
2302 |
0,13 |
1085 |
2293 |
0,47 |
Гуминовые кислоты и фульвокислоты, выделенные из компостов и вермикомпостов различного происхождения, анализировали методом высокоэффективной жидкостной хроматографии. В ходе эксперимента были использованы следующие компосты и вермикомпосты: конский, птичий, свиной, осадок сточных вод. Вермикомпосты получены в течение 6 месяцев с мая по октябрь 2004 года.
Выделение гуминовых и фульвокислот из компостов и вермикомпостов проводили в соответствии с требованиями Международного гуминового общества (Gaffney S., Marley N.A. and Clark S.B., 1996).
 а)
а)
 б)
б)
 в)
в)
Рисунок 6. Гумусовые кислоты, выделенные из вермикомпоста червя "Старатель": а) гуминовые кислоты, б) фульвокислоты, в) гиматомелановые кислоты.
Из одинаковых по массе сухих навесок была определена влажность препаратов с использованием метода высушивания до постоянного веса. Содержание влаги в вермикомпостах существенно выше, чем в компостах. Разность во влагоемкости между компостами и вермикомпостами составила от 22,6% до 37,9%, таким образом влагоудерживающая способность вермикомпостов существенно выше, чем соответствующих компостов.
В таблице 7 приведены данные по экстрагируемости веществ 0,1N HCl из компостов и вермикомпостов. Следует отметить, что наибольшее количество экстрагируемых веществ получено из конского компоста и вермикомпоста. Наименьшее - из осадка сточных вод и вермикомпоста на его основе. Анализ данных таблицы показывает, что экстрагируемость веществ из вермикомпостов ниже по сравнению с компостами на 4-16%.
Таблица 7 Экстрагируемость веществ из компостов и вермикомпостов раствором 0,1N HCl
| № п/п |
Источники компостов и вермикомпостов |
Концентрация Экстрагируемых веществ, мг/мл |
Изменение экстрагируемости вермикомпостов и компостов, % |
| 1 |
Конский компост |
7,8 |
10,2 |
| Конский вермикомпост |
7,0 |
||
| 2 |
Птичий компост |
6,7 |
4,3 |
| Птичий вермикомпост |
6,3 |
||
| 3 |
Свиной компост |
6,3 |
7,9 |
| Свиной вермикомпост |
5,8 |
||
| 4 |
ОСВ |
5,5 |
16,4 |
| Вермикомпост на основе ОСВ |
4,6 |
Для хроматографических исследований использовали растворы гуминовых кислот с концентрацией 1мг/мл и фульвокислот с концентрацией 2мг/мл. В работе использовали колонку - Macrosphere C8 (300A) (250x4.6). Ион-парную хроматографию проводили в присутствии в элюенте 6 мМ ТБА (тетрабутил - аммоний бромид). Детектирование хроматографических пиков проводили УФ детектором при 280 нм.
Хроматограммы гуминовых кислот содержали по два пика. Вещества пика – 1 гидрофильные, так как элюировались с колонки водой и имели низкие времена удерживания. Вещества пика - 2 гидрофобные, элюировались с колонки ацетонитрилом. Хроматографический пик 1, соответствующий гидрофильным гуминовым кислотам при проведении ион-парной хроматографии исчезает, а площадь под пиком 2 (гидрофобные гуминовые кислоты), соответственно возрастает. Такое поведение характерно для всех образцов гуминовых кислот. Полученные результаты дают основание считать, что различие между пиками 1 и 2 на рисунках 7 (а, б) и 8 (а, б) определяется в основном содержанием в ГК ионизованных групп. Учитывая, что исследование было выполнено при pH=7,6 речь идёт о карбоксильных группах, имеющих для гуминовых кислот pK - 3,6-4,6. По данным Перминовой (2000), содержание этих групп для большого массива гуминовых кислот, полученных из различных источников, составляет 3 -7 мМоль/г. Следует отметить, что карбоксильные группы присутствуют и в гидрофобной фракции гуминовых кислот (рис. 7, пик 2), так как при введении в элюент ТБА время выхода гидрофобной фракции возрастает с 28 до 31 мин, а пик становится более симметричным (рис. 8), что свидетельствует о более высокой однородности гуминовых кислот при нивелировании их зарядов.
 а)
а)
 б)
б)
Рисунок 7. Хроматограмма гуминовых кислот, выделенных из конского компоста (а) и вермикомпоста (б) без ТБА в элюенте. детектирование - 280 нм, режим: изократический 10 мин элюент А; градиент от 100% А до 95% В c 10 до 30 мин; изократический - 95% В с 30 до 40 мин. Элюент-А -10 мМ фосфатный буфер с рН=7,6; элюент – B - 100% ацетонитрил.
 а)
а)
 б)
б)
Рисунок 8. Хроматограммы гуминовых кислот выделенных из конского компоста (а) и вермикомпоста (б) c ТБА в элюенте, детектирование 280нм, режим: изократический 10 мин элюент - А; градиент от 100% А до 95% В c 10 до 30 мин; изократический - 95% В с 30 до 40 мин. Элюент-А 10 мМ фосфатный буфер с рН=7,6 содержащий 6мМ ТБА (тетрабутил-амоний бромида); элюент - В- 100% ацетонитрил содержащий 6мМ ТБА.
Таким образом, в процессе вермикомпостирования наблюдается возрастание влагоудерживающей способности вермикомпостов; снижение экстрагируемости гуминовых веществ 0,1N раствором HCl; снижение экстрагируемости фульвокислот; возрастание удельной ароматичности суммарных фракций гуминовых кислот; возрастание удельной ароматичности суммарных фракций фульвокислот и существенный рост ароматичности гидрофильной фракции ФК.
Содержание ароматических фракций может служить в какой-то мере показателем степени гумификации вермикомпостов при их качественной оценке. Однако, в настоящее время не разработан однозначный параметр для оценки приемлемых уровней стабильности и зрелости компоста. Для компетентного заключения о степени гумификации необходимо рассмотреть как можно больше возможных показателей стабильности вермикомпоста.
5. Термодинамические свойства гуминовых веществ
Для оценки степени завершенности процесса гумификации вермикомпостов был использован метод дифференциальной сканирующей микрокалориметрии. На рисунке 9 приведены термограммы для растворов комплекса гуминовых веществ, выделенных из вермикомпостов различного периода созревания. Термограммы имеют общий вид. Температурные зависимости теплоемкостей (Ср ) на участках А-В термограмм возрастают с ростом температуры до ~60°С. Начиная с точки В, температурные зависимости теплоемкостей меняют наклон (участок В-С), то есть, температурные зависимости теплоемкости на участке А-В имеют больший положительный температурный инкремент (∂С/∂T > 0), чем на участке В-С. Таким образом, при температуре ~60°С наблюдается некоторое изменение в состоянии гуминовых веществ.

Рисунок 9. Термограммы растворов гуминовых веществ выделенных из вермикомпостов различного периода созревания:
1 - образец-0, 2 - зимний образец, 3 - летний образец.
Tm – температура средины перехода при разрушении мицелл,
∆T- интервал перехода,
∆Cр - скачок теплоемкости.
После точки В при температуре ~60°С температурный инкремент теплоемкости (∂С/∂T) уменьшается.
Возможно, излом температурной зависимости теплоемкости связан с возрастанием силы гидрофобных взаимодействий до температуры ~70°С, а при более высокой температуре она начинают ослабевать, что проявляется на участке В-С в более низком температурным инкременте. На участке С-Д теплоемкости всех образцов гуминовых веществ скачкообразно возрастают в узком температурном интервале.
Учитывая этот факт и то, что гуминовые вещества в растворах образуют мицеллы, наблюдаемый термический переход можно отнести к разрушению мицелл, а скачок теплоемкости (ΔСр ) связать с площадью гидрофобных групп, экспонированных в водный растворитель при разрушении мицелл.
Установление корреляционной зависимости между термодинамическими параметрами разрушения мицелл гуминовых веществ и спектральными параметрами, полученными из хроматографических данных, показало, что возрастание относительной степени ароматичности приводит к линейному росту ΔСр (R²=0,998). Как было отмечено выше, разрушение мицелл сопровождается экспонированием в воду гидрофобных групп гуминовых веществ ранее не доступных растворителю. Так как ароматические группы гуминовых веществ являются гидрофобными, то наблюдалось увеличение скачка теплоемкости с ростом ароматичности. Другими словами, мицеллы гуминовых веществ, полученные из вермикомпоста более высокой степени зрелости, содержат большее количество гидрофобных групп не доступных растворителю, которые при разрушении мицелл экспонируются в воду и дают большее значение ΔСр .
Рост степени ароматичности гуминовых веществ приводит к линейному росту ΔТ (R² = 0,941). Возрастание температурного интервала разрушения мицелл, вероятно, связано с ростом их гетерогенности.
Возрастание суммарной степени ароматичности гуминовых веществ приводит к линейному снижению температуры средины перехода (Тm ) (R²= 0,967).
На основании проведенных исследований можно рассматривать возможность использования термического анализа для контроля степени гумификации и характеристики химических изменений в органическом веществе компоста.
Методом прецизионной дифференциальной сканирующей микроколориметрии и методом ВЭЖХ в обращенных фазах исследовали гуминовые кислоты, выделенных из вермикомпостов различного периода созревания. Концентрация гуминовых кислот в растворах составляла 6 мг/мл.
Термограммы трех образцов гуминовых кислот (1-образец-0 (компост); 2-зимний образец; 3- летний образец) сходны (рис. 10).
Теплоемкости (Ср) на участках А-В термограмм возрастают с ростом температуры до 58°С. Начиная с точки В теплоемкости снижаются (участок В-С), то есть температурные зависимости теплоемкости на участке А-В имеют положительный температурный инкремент (∂С/∂T>0), а на участке В-С – отрицательный (∂С/∂T<0). По видимому, при температуре 58°С наблюдается изменение в состоянии гуминовых кислот, которое соответствует термодинамическому переходу 3-го рода (∂С/∂T- меняет знак). На участке С-Д теплоемкости для образцов гуминовых кислот скачкообразно возрастают в узком температурном интервале. Определены термодинамические характеристики этого перехода: ширина перехода - ΔТ, средина перехода -Тс и разность теплоемкостей - ΔСр .
|
|
|
|

Рисунок 10. Термограммы растворов гуминовых кислот, выделенных из вермикомпостов различной степени зрелости:
1 - образец-0, 2 - зимний образец, 3 - летний образец.
Tc – температура расстекловывания,
∆T- интервал перехода расстекловывания,
∆Cр - скачок теплоемкости при расстекловывании ГК.
В точке В при температуре 58°С температурный инкремент теплоемкости (ðС/ðT) меняет знак с "+" на "-".
В таблице 8 приведены термодинамические характеристики переходов, а также данные для процессов расстекловывания синтетических полимеров. Учитывая этот факт и то, что гуминовые кислоты в растворах образуют ассоциаты, можно предположить, что эти надмолекулярные структуры находятся в растворах в стеклообразном состоянии. В ходе сравнения термодинамических параметров расстекловывания гуминовых кислот выявлено, что значения ΔСр для образцов практически одинаковы, однако значения ΔТ и Тс различаются.
Таблица 8 Термодинамические параметры расстекловывания гуминовых кислот, полученных из вермикомпостов различной степени зрелости
Наименованиеобразца |
TC ,ºC |
ΔT,ºC |
ΔCP , Дж/гК |
*Синтетические полимеры |
|
| ΔT,ºC |
ΔCP , Дж/гК |
||||
| контроль |
86,1 ±0,2 |
8,5 ±0,5 |
0,28 ±0,02 |
7 - 10 |
0,3 – 0,5 |
| зимний |
87,2 ±0,2 |
7,3 ±0,4 |
0,32 ±0,03 |
||
| летний |
90,2 ±0,2 |
4,2 ±0,6 |
0,28 ±0,02 |
||
*Данные взяты из монографии: Дифференциальная сканирующая калориметрия в физикохимии полимеров, Бернштейн В.А., Егоров В.М., - Ленинград, изд. Химия, 1990 г, стр. 248.
Данные хроматографического анализа растворов гуминовых кислот показали наличие двух фракций – гидрофильной и гидрофобной. Выявлено, что процентное содержание фракции-2 возрастает в соответствии с ростом зрелости вермикомпоста в ряду: образец – летний > образец - зимний > контроль. Содержание фракции-2 (%) определено как отношение площади хроматографического пика-2 к сумме площадей под пиками 1 и 2 при детектировании пиков 220 нм (S2 220 / ΣS220 ). Содержание фракции-2 в образцах в 2 раза превышает ее содержание в компосте.
Относительная алифатичность определена как отношение площади под пиком при детектировании при 220 нм к площади при детектировании при 280 нм (S2 220 /S2 280 ). Показано, что с ростом зрелости вермикомпоста относительная алифатичность фракции-2 в 2 раза возрастает. В то же время, процентное содержание фракции-1 падает и ее относительная алифатичность снижается. Суммарная алифатичность определена как отношение суммы площадей под пиками хроматограмм фракций-1 и 2 при детектировании 220 нм к сумме площадей этих фракций при детектировании 280 нм (ΣS220 /ΣS280 ). Отмечено, что она возрастает с ростом зрелости вермикомпоста.
В настоящее время наиболее объективным критерием зрелости и стабильности компостов считается критерий относительного содержания фракции ядра (core) в общей сумме гуминовых кислот (Adani F., Genevini P.L., 1997; Chefetz B, Adani F., 1998). Эта фракция представляет собой высокомолекулярную алифатическую (гидрофобную) фракцию гуминовых кислот и накапливается в процессе компостирования. В качестве критерия зрелости компостов предложен индекс стабильности компоста, представляющий собой отношение углерода суммарных гуминовых кислот к углероду фракции ядра. В нашем случае фракцией ядра является хроматографическая фракция-2 (алифатическая), рост содержания которой в гуминовых кислотах отражает степень зрелости или степень гумификации вермикомпоста. Однако, наиболее подходящим критерием степени зрелости вермикомпоста является критерий роста относительной суммарной алифатичности гуминовых кислот, так как в нем учтены спектральные свойства, как фракции-1, так и фракции-2, кроме того относительная суммарная алифатичность линейно связана с температурой расстекловывания гуминовых кислот. Увеличение содержания фракции-2 приводит к экспоненциальному росту Тс , в то же время, температурный интервал расстекловывания - ΔT уменьшается. Эти данные свидетельствуют о росте кооперативности процесса расстекловывания гуминовых кислот, что связанно с количественным возрастанием фракции-2, которая является более высокомолекулярной и алифатичной по-сравнению с фракцией-1.
На основании экспериментальных данных можно заключить, что степень гумификации вермикомпостов можно контролировать:
1. методом ВЭЖХ в обращенных фазах, используя как критерий: относительную суммарную алифатичность гуминовых кислот;
2. методом сканирующей микроколориметрии, используя как критерий температуру расстекловывания и температурные интервалы расстекловывания гуминовых кислот.
Результаты, полученные методом сканирующей микроколориметрии, подтверждаются данными ЯМР-спектроскопии.
Анализ молекулярной структуры препаратов ГК показал, что с увеличением периода вермикомпостирования увеличивается содержание О-алкильных функциональных групп (с 15% до 33%) и уменьшается доля ароматических молекулярных фрагментов (с 34% до 20%).
6. Испытание биологической активности гуминового комплекса вермикомпоста
Для выявления особенностей ферментативной активности вермикомпоста были отобраны и проанализированы образцы почвы компоста и вермикомпоста. В исследуемых образцах изучали ферменты класса оксидоредуктаз. В контрольных образцах (неферментативная активность) ферменты инактивировали стерилизацией сухим жаром при температуре 180 °С в течение двух часов. За единицу активности (Е) принимали величину оптической плотности, отнесенную к сухой массе навески. Анализ диаграммы (рис. 11-а) показал, что самая высокая каталазная активность наблюдалась в варианте с вермикомпостом. Следует отметить что, активность фермента возрастает по мере созревания вермикомпоста.
![]() а)
а)
 б)
б)
Рисунок 11. Активность каталазы (а), пероксидазы (б) в образцах почвы, биогумуса и компоста.
Пероксидазам присущи процессы окисления органического вещества или косвенного распада гумуса, в то время как полифенолоксидазы участвуют в превращениях органических соединений ароматического ряда в компоненты гумуса. Оба процесса взаимосвязаны. Активность пероксидазы в контроле составила 5,5, в почве в воздушно-сухом состоянии 7, в компосте 8,5 условных единиц (рис. 11-б). В образцах биогумуса активность пероксидазы возросла почти в 2 раза и составила 10,5 условных единиц.
Повышенная оксидазная активность вермикомпоста объясняется, вероятно, тем, что копролиты являются центрами микробиологической активности в почве. В каждом грамме биогумуса содержится более 50 млрд. микробных клеток. Поглощая почву и органические вещества, черви выделяют с копролитами большое количество собственной кишечной микрофлоры, ферментов, витаминов, которые в свою очередь обладают стимулирующим действием на активность и биомассу микроорганизмов, являющихся продуцентами различных биологически активных веществ.
Изучение влияния гуминового комплекса, выделенного из вермикомпостов, на активность пероксидазы и каталазы на начальных стадиях развития гороха проводили на контрастных по устойчивости сортах: сорт "Норд", не устойчивый к вредителям и болезням и сорт "Орпела", обладающий комплексной устойчивостью к неблагоприятным факторам. Ранее установлено, что биологически активную основу гуминового комплекса составляют гуминовые кислоты, фульвокислоты и гиматомелановые кислоты, оказывающие стимулирующее воздействие на растения.
Активность ферментов исследовали в проростках на третий, пятый и пятнадцатый день после замачивания. Контрольные семена замачивались в воде, препаратами сравнения служили – раствор вытяжки из компоста и промышленный препарат "Гумистар".
Исследование пероксидазной активности на проростках гороха "Норд" (3-и сутки) показало, что в контроле активность самая низкая (84 у.е.). В образцах, обработанных препаратом "Гумистар" и раствором гуминового комплекса с концентрацией 1,5×10-4 %, активность пероксидазы высокая (245 и 216,46 у.е. соответственно). В варианте с вытяжкой из компоста активность повысилась незначительно по сравнению с контрольным вариантом (134,44 у.е.). Активность пероксидазы в проростках гороха в варианте с раствором препарата "Гумистар" была несколько выше, чем в варианте с раствором гуминового комплекса.
Самая низкая активность пероксидазы у сорта Норд наблюдалась в контроле и в варианте с вытяжкой из компоста. При обработке семян раствором гуминового комплекса с концентрацией 1,5∙10-3 %, отмечено значительное возрастание активности пероксидазы до 4500 у.е. Раствор гуминового комплекса с концентрацией 1,5∙10-4 % показал близкие результаты. Это свидетельствует о том, что растворы с низкой концентрацией активного вещества действует так же эффективно при меньшем расходе препарата.
Активность пероксидазы проростков у сорта "Орпела" различается незначительно по вариантам. Причем, в контрольном варианте эти показатели были самыми низкими. Более высокая активность наблюдалась в варианте с раствором "Гумистар". Растворы гуминового комплекса с концентрациями 1,5×10-4 % и 1,5×10-3 % показали аналогичные результаты. Тенденция по закономерностям аналогична сорту "Норд".
Активность каталазы в проростках неустойчивого сорта "Норд" (3-и сутки) по вариантам изменялась от 0,81 до 2,1 у. е. У сорта "Орпела" наиболее низкая активность фермента выявлена в контроле (7,3 у.е.). Относительно высокая - в варианте с вытяжкой из компоста (10,5 у.е.). Активность образцов, обработанных растворами гуминового комплекса и препаратом "Гумистар", различалась незначительно.
Таким образом, у сорта "Норд" активность пероксидазы во всех вариантах на несколько порядков больше, чем у сорта "Орпела". А активность каталазы, напротив, во всех вариантах ниже по сравнению с пероксидазой. Снижение активности каталазы, возможно, связано с накоплением активных форм кислорода в форме перекисей и конкурентным действием пероксидазы, активность которой возросла.
В 5-ти суточных проростках прослеживались те же закономерности - у устойчивого сорта активность пероксидазы на несколько порядков выше, чем у неустойчивого.
Активность каталазы в корешках у неустойчивого сорта "Норд" по вариантам исследования изменялась от 2 до 3,62 у.е. У сорта "Орпела" активность фермента во всех вариантах выше, чем у сорта "Норд".
В 15–суточных проростках у сорта "Норд" активность пероксидазы низкая в контроле и в варианте с вытяжкой из компоста. При обработке семян растворами гуминового комплекса отмечено значительное возрастание активности пероксидазы до 2423 у.е. для раствора с концентрацией 1,5∙10-4 %. В варианте с препаратом "Гумистар" активность фермента была ниже, чем в вариантах с растворами гуминового комплекса. У сорта "Орпела" наблюдалась та же закономерность. Самая низкая активность в контрольном варианте и варианте с вытяжкой из компоста, а самая высокая для раствора гуминового комплекса с концентрацией 1,5∙10-4 %. Активность при обработке препаратом "Гумистар" ниже, чем при обработке растворами гуминового комплекса.
Анализ полученных результатов показал, что при обработке растений раствором гуминового комплекса удаётся индуцировать иммунитет у растений; поскольку обработка семян вызывает биохимические изменения в тканях; в обработанных гуминовым комплексом растениях активность пероксидазы увеличивается, а поскольку возрастание пероксидазной активности свидетельствует о повышении иммунного статуса, можно предположить, что гуминовый комплекс выступает элиситором индуцированного иммунитета. Обработка гуминовым комплексом сохраняет уровень пероксидазы в проростках на достаточно высоком уровне, что позволяет растению защититься от болезней на этапе развития, когда иммунитет понижен. Пероксидасомы растительных клеток играют фундаментальную роль в защите от патогенов, усиление их функции с помощью гуминового комплекса может явиться новой формой биологической защиты растений.
Активность супероксиддисмутазы (СОД) исследована на среднеустойчивом сорте гороха "Батрак". Активность ферментов измеряли в побегах и корешках проростков на третий, пятый, седьмой и десятый день после замачивания семян.
На основании проведенных исследований выявлено, что активность СОД во всех вариантах увеличивается на седьмой день развития побега и составляет около 15000 у.е. (рис. 12-а). На третий день прорастания самая высокая активность отмечена в варианте с раствором гуминового комплекса. На десятый день развития проростка активность СОД падает во всех вариантах. Стимуляция гуминовым комплексом активности СОД, вероятно, связана с его высокой способностью к детоксикации активных форм кислорода. Исследования активности СОД в корешках проростков гороха "Батрак" подтвердили полученную закономерность, выражающуюся в повышении активности антиоксидантных ферментов под влиянием гуминового комплекса (рис. 12-б).
 а)
а)
 б)
б)
Рисунок 12. Влияние гуминового комплекса на активность СОД: a) в побегах, б) в корешках проростков гороха сорта "Батрак". Варианты: 1 – контроль (вода), 2 – препарат "Нарцисс", 3 – препарат "Винцит, СК", 4 – препарат гуминового комплекса, 1,5·10-4 %.
Применение гуминового комплекса способствует повышению активности пероксидазы и каталазы, как индикаторов увеличения устойчивости к неспецифическим патогенам, а также усиливает ростовые процессы на стадии проростков. При обработке гуминовым комплексом индукционный эффект был более выражен, что делает возможным использование его для создания препарата широкого спектра действия. Одним из наиболее многообещающих способов защиты растений является индуцирование их устойчивости.
Гуминовый комплекс является одним из препаратов природного происхождения, биоактивные вещества которого, попадая в клетку, подают сигнал растению, для активации антиоксидантных ферментов, помогающим растению бороться с негативным действием биотических факторов.
Подобное усиление иммунитета гороха под влиянием гуминового комплекса не могло не сказаться на устойчивости растений при испытании в полевых условиях. Устойчивость растений к болезням и вредителям один из важных факторов, определяющих высокие урожаи сельскохозяйственных культур и его стабильность. Разработка путей эффективного решения этой проблемы имеет большое народнохозяйственное значение.
В ходе эксперимента исследовано влияние препарата гуминового комплекса на зараженность семян, развитие корневых гнилей, аскохитоза, а также устойчивость к поражению вредителями. Эксперимент проводился в трех вариантах: обработка вытяжкой из компоста, препаратом гуминового комплекса с концентрацией раствора 1,5×10-4 %, препаратом гуминового комплекса с концентрацией раствора 1,5×10-3 %, контроль – вариант без обработки.
Сорт "Вега" овощного использования, в начале вегетации растёт медленно, поэтому сильнее зарастает сорняками, поражается болезнями и повреждается вредителями, не устойчив к корневым гнилям, средне устойчив к аскохитозу, не устойчив к тле. Результаты лабораторного опыта на бактериальную заражённость показали, что заражённость семян во всех вариантах ниже, чем в контроле (табл. 9).
Таблица 9 Влияние обработки препаратом гуминового комплекса гороха сорта "Вега" на заражённость семян, развитие корневых гнилей, развитие аскохитоза
| Вариант |
Заражённость семян, % |
Корневые гнили, % развития |
Развитие аскохитоза, % |
|
| Фаза цветения |
Фаза плодообразования |
|||
| Контроль (без обработки) |
35,0 |
32,9 |
45,4 |
51,0 |
| Предпосевная обработка семян |
||||
| Вытяжка из компоста |
22,5 |
27,5 |
42,1 |
46,4 |
| Препарат гуминового комплекса, 1,5×10 -4 % |
18,5 |
25,4 |
40,8 |
48,0 |
| Препарат гуминового комплекса, 1,5×10 -3 % |
20,0 |
25,4 |
43,0 |
55,1 |
| Предпосевная обработка семян + 2- кратным опрыскивание |
||||
| Вытяжка из компоста |
22,0 |
0,0 |
0,0 |
0,0 |
| Препарат гуминового комплекса, 1,5×10 -4 % |
21,5 |
0,0 |
0,0 |
0,0 |
| Препарат гуминового комплекса, 1,5×10 -3 % |
28,0 |
0,0 |
0,0 |
0,0 |
| НСР 05 |
2,3 |
12,0 |
1,8 |
7,1 |
Под влиянием предпосевной обработки семян испытуемыми растворами снижается процент развития корневых гнилей как в фазу цветения, так и в фазу плодообразования, по сравнению с контролем (без обработки). Предпосевная обработка семян в сочетании с 2- кратным опрыскиванием привела к полному подавлению болезни в вариантах с препаратом гуминового комплекса и вытяжкой из компоста (табл. 9).
Развитие аскохитоза на горохе сорта "Вега" при предпосевной обработке семян по вариантам незначительно отличается от контроля. Это можно объяснить тем, что аскохитоз развивается на всходах и надземных органах взрослых растений. В вариантах с предпосевной обработкой семян и 2-кратным опрыскиванием растений наблюдалось полное подавление болезни (табл. 9).
Развитие тли в культуре гороха сорта "Вега" (на 10 взмахов сачка) в вариантах с препаратом гуминового комплекса с концентрацией раствора 1,5×10-3 % и вытяжкой из компоста составило 245 и 252 шт. соответственно. А в варианте с препаратом гуминового комплекса с концентрацией раствора 1,5×10-4 % всего 84 шт. Меньшая концентрация раствора препарата гуминового комплекса оказалось более эффективной в вариантах с предпосевной обработкой семян сочетающейся с двукратным опрыскиванием растений. В этом случае наблюдалось полное подавление развития тли.
При анализе биологической эффективности применения препарата гуминового комплекса на горохе сорта "Норд" рассмотрен показатель развития корневых гнилей в фазу бутонизации и в фазу плодообразования. Сорт имеет среднюю устойчивость к поражению болезнями и вредителями. Наименьший процент развития корневых гнилей в фазу бутонизации, был отмечен в варианте с препаратом гуминового комплекса (концентрация 1,5×10-4 %) (табл. 10).
Таблица 10 Влияние обработки препаратом гуминового комплекса гороха сорта "Норд" на поражаемость болезнями
| № п/п |
Варианты |
Развитие корневых гнилей,% фаза бутонизации |
Развитие корневых гнилей,% фаза плодообразования. |
Ржавчина, % фаза развития |
Аскохитоз, % фаза развития |
| 1 |
Контроль (без обработки). |
41,8 |
70,6 |
57,8 |
27,5 |
| Предпосевная обработка семян |
|||||
| 2 |
Препарат гуминового комплекса, 1,5×10-3 % |
38,1 |
46,8 |
50,5 |
20,0 |
| 3 |
Препарат гуминового комплекса, 1,5×10 -4 % |
35,2 |
46,2 |
51,8 |
20,2 |
| Предпосевная обработка семян + 2-кратное опрыскивание |
|||||
| 4 |
Препарат гуминового комплекса, 1,5 × 10-4 % |
41,5 |
0,0 |
51,2 |
22,0 |
| 5 |
Препарат гуминового комплекса, 1,5 × 10-5 % |
39,8 |
0,0 |
51,8 |
20,0 |
| 6 |
Контроль (без обработки). |
45,8 |
0,0 |
57,8 |
27,5 |
| 7 |
НСР05 |
13,08 |
13,01 |
10,11 |
7,11 |
У варианта без обработки семян развитие корневых гнилей составило 41,8%. Низкий процент развития корневых гнилей наблюдался и при обработке препаратом более низкой концентрации. Заметно повышается процент развития корневых гнилей в фазу плодообразования, но во всех вариантах он ниже по сравнению с контролем (70,6%), у варианта с обработкой семян раствором гуминового комплекса с концентрацией 1,5×10-4 %, развитие болезни составляет 46,2 %. Предпосевная обработка семян в сочетании с двукратным опрыскиванием позволяют снизить заболеваемость растений в фазу бутонизации, и полностью подавить развитие корневых гнилей в фазу плодообразования. Во всех вариантах с применением обработки препаратом гуминового комплекса отмечено снижение развития ржавчины и аскохитоза по сравнению с контролем.
Обработка семян гороха сорта "Норд" препаратом гуминового комплекса отразилась на урожайности культуры. Как и в предыдущих исследованиях, наиболее эффективным оказалось сочетание предпосевной обработки семян с 2-х разовым опрыскиванием растений растворами гуминового комплекса. В варианте с раствором 1,5×10-3 % концентрации прибавка урожайности составила 30,6%, а в варианте с раствором 1,5×10-4 % концентрации она увеличилась почти в два раза (на 91,9 %) и составила 2,63 т/га, что превышает среднюю урожайность данного сорта по области.
В полевом эксперименте, поставленном в 2004 – 2007 годах было исследовано влияние гуминового комплекса на развитие и урожай гороха (сорт "Норд"), картофеля (сорт "Жуковский ранний"), пшеницы (сорт "Крестьянка").
Из данных таблицы 11 следует, что препарат гуминового комплекса оказал положительное влияние на картофель сорта "Жуковский". Так, количество клубней и их вес увеличились, а урожайность повысилась на 30-40% (от 18 т/га в контроле – до 25-28 т/га при обработке раствором гуминового комплекса с концентрациями 1,5×10-3 % и 1,5×10-4 % соответственно).
Таблица 11 Влияние препарата гуминового комплекса на урожай сельскохозяйственных культур
| Вариант |
Картофель "Жуковский ранний" |
Пшеница яровая "Крестьянка" |
Горох "Норд" |
|||||
| Кол-во клубней на один куст, шт. |
Масса клубней 10 смежных кустов, кг |
Урожайность, т/га |
Всходы, шт./м2 |
Масса 1000 семян, г. |
Урожай, т/га. |
Масса 1000 семян, г. |
Урожайность, т/га |
|
| Контроль |
5,0 |
3,78 |
18,0 |
160,0 |
19,0 |
1,70 |
120,7 |
1,5 |
| Препарат гуминового комплекса, 1,5×10 -2 % |
6,0 |
4,20 |
20,0 |
194,0 |
36,0 |
2,1 5 |
130,8 |
1,8 |
| Препарат гуминового комплекса, 1,5×10 -3 % |
8,0 |
5,25 |
25,0 |
170,0 |
26,0 |
1,95 |
151,3 |
2,2 |
| Препарат гуминового комплекса, 1,5×10 -4 % |
7,0 |
5,88 |
28,0 |
184,0 |
24,0 |
1,98 |
180,8 |
2,9 |
| Вытяжка из компоста |
6,0 |
3,99 |
19,0 |
149,0 |
20,0 |
1,75 |
111,5 |
1,7 |
| НСР 05 |
1,67 |
0,4 |
0,70 |
1,38 |
0,52 |
0,12 |
0,49 |
0,09 |
Испытание влияния препарата гуминового комплекса на урожайность проводили на яровой пшенице сорта "Крестьянка". В таблице 11 показано, что под влиянием препарата гуминового комплекса с концентрациями 1,5×10-3 % и 1,5×10-4 % количество семян на 1м2 увеличивается от 160,0–в контроле (вода) до 194,0 и 184,0 шт. соответственно по вариантам. Под влиянием вытяжки из компоста произошло угнетение развития семян.
Масса тысячи семян возросла в большей степени под влиянием раствора гуминового комплекса с более высокой концентрацией (с 19,0 до 36,0 г.), что отразилось на урожае зерна 1,7 т/га – в контроле и 2,15 т/га в варианте с концентрацией гуминового комплекса 1,5×10-2 %. Однако, более низкие концентрации растворов (1,5×10-3 % и 1,5×10-4 %) также сказались на увеличении урожайности пшеницы до 1,95 и 1,98 т/га соответственно.
Следует отметить, что под влиянием препарата гуминового комплекса происходит увеличение всхожести семян пшеницы на 20%, наблюдается увеличение высоты растений.
Обработка гороха препаратом гуминового комплекса проводилось на сорте "Норд" (табл. 11). Из данных следует, что под влиянием растворов препарата с концентрациями 1,5×10-2 %, 1,5 10-3 %, 1,5×10-4 % масса тысячи семян возросла во всех случаях. Лучший результат отмечен в варианте с раствором меньшей концентрации 1,5×10-4 %. Масса тысячи семян в этом случае возросла со 120,7 (контроль) до 180,8. Этот вариант показал наибольшую урожайность - 2,9 т/га (в контроле 1,5 т/га).
Под влиянием препарата гуминового комплекса, в частности, при замачивании клубней картофеля в растворе препарата наблюдалось увеличение высоты растений, увеличение площади листьев до 200 см2 , а при опрыскивании растения в стадии цветения до 126,4 см2 по сравнению с контролем 117,5 см2 .
Данный показатель у пшеницы и гороха в случае замачивания семян и опрыскивания растений также превышает контроль на 30 и 29% соответственно. Замачивание посевного материала в вытяжке из компоста и опрыскивание этой же вытяжкой показало результат несколько ниже контроля, этот показатель у картофеля составляет 96 см2 и 114,3 см2 ; у пшеницы 129,0 см2 и 146,2 см2 , а у гороха 108,0 см2 и 111,8 см2 соответственно.
Химический состав клубней картофеля в вариантах с использованием растворов препарата гуминового комплекса характеризовался повышением содержания азота. Кроме того, повысилось содержание крахмала. Обработка растений раствором препарата гуминового комплекса положительно повлияла на сохранность картофеля при хранении. Количество клубней, пораженных бактериальной гнилью снизилось в 2 раза относительно контроля. Поражение фитофторозом снизилось на 15%, а фузариозом на 10%.
Таким образом, полученные данные убедительно показывают положительное влияние препарата гуминового комплекса на рост, развитие и урожайность таких культур как картофель, пшеница, а также горох.
Применение созданных на основе вермикомпоста препаратов для обработки сельскохозяйственных растений способствует улучшению экологической обстановки за счет таких факторов как снижение использования высокотоксичных и дорогостоящих химических средств защиты; исключение их негативного воздействия на окружающую среду, человека и животных, полезных организмов составляющих почвенную фауну.
Полученные данные говорят о широком спектре действия препарата гуминового комплекса, в том числе участии в защитных механизмах растений, иммуностимулирующем и координирующем действии на рост и развитие растений. Препараты, созданные на основе вермикомпоста - биологические аналоги естественных факторов, поэтому они не могут вызвать отрицательных явлений в процессе роста и развития растений при научно-обоснованном применении.
Основные выводы
1. Получен вермикомпост (биогумус) на основе отечественного гибрида дождевого червя "Старатель" из разных видов компостов;
2. Освоена методика выделения гумусовых кислот. Разработана и применена одноступенчатая оптимизированная методика выделения гумусовых кислот. Разработан и применен метод ВЭЖХ в обращенных фазах для хроматографической характеристики ГК, ФК, ГМК.
3. Определен ключевой показатель оценки скорости биоконверсии органических субстратов и степени зрелости вермикомпостов - соотношение C/N, оно снижается от 22,1 – в компосте до 13,7, 17,8 в зимнем и летнем образцах биогумуса соответственно.
4. На основании систематических исследований установлены закономерности изменения микробиологической и ферментативной активности компостов и вермикомпостов:
- в процессе созревания вермикомпост обогащается грибами-антагонистами (Trichoderma), приобретая свойства оздоравливающего действия;
- аммонифицирующая активность в образцах вермикомпостов значительно повышается по сравнению с компостом в 2,6 и 1,8 раз соответственно для летнего и зимнего образцов;
- нитрифицирующая активность снижается: от 19,2 мг в компосте до 17,8 и 17,6 – в летнем и зимнем образцах вермикомпостов;
- препараты зимних образцов биогумуса обладают более высокой протеолитической активностью, чем препараты летнего, образцы компоста, не обработанного червями, не обладают протеолитической активностью;
- амилолитической активности обнаружить не удалось ни в одном из образцов.
5. Методом гель-хроматографии определены молекулярные массы белков биогумуса (»27 кДа) и жирнокислотный состав в исследованных препаратах. Показано, что содержание жирных кислот в препаратах биогумуса выше, чем в препарате, не обработанном червями (контроль).
6. На основании исследований и анализа экспериментальных данных можно заключить, что
- влагоудерживающая способность вермикомпостов по сравнению с компостами возрастает;
- с ростом степени гумификации экстрагируемость гумусовых веществ снижается;
- удельная ароматичность суммарных фракций ГК (гидрофильной и гидрофобной) возрастет;
- удельная ароматичность суммарных фракций ФК возрастет, наблюдается существенный рост ароматичности гидрофильной фракции ФК, содержащей малополярные заместители в молекулах;
- предпочтительным спиртом для экстракции ГМК является этанол; - в исследованных образцах гумусовых кислот содержится около 20%(w/w) ГМК;
- относительная степень ароматичности ГМК в процессе гумификации не изменяется;
- с ростом степени гумификации наблюдается снижение содержания карбоксильных, карбонильных и фенольных групп в ГМК.
7. Исследования вермикомпостов, полученных из разных субстратов показали, что процессы вермикомпостирования для различных компостов различаются как по интенсивности гумификации (различия в приросте удельной ароматичности суммарных фракций), так и по механизмам гумификации (различия в приросте гидрофильной и гидрофобной фракций);
8. Исследования методом сканирующей микрокалориметрии показали, что ГК в разбавленных водных растворах находятся в виде "мицелл" и содержат две фракции гидрофильную и гидрофобную; в процессе вермикомпостирования содержание гидрофобной фракции увеличивается и возрастает ее алифатичность.
9. Метод 13 С ЯМР-спектроскопии показал, что исследованные препараты ГК, разного срока созревания различаются по соотношению ароматических и углеводных фрагментов, входящих в состав углеродного скелета. Были идентифицированы и количественно определены следующие функциональные группы и молекулярные фрагменты: ароматические (- Ar), карбоксильные (-СООН), карбонильные (-С=О), алкильные (Alk), О-замещенные алифатические атомы углерода (Alk-O).
10. Разработана общая методология контроля степени гумификации с помощью:
а) метода ВЭЖХ, используя как критерий относительную суммарную ароматичность ГВ;
б) метода сканирующей микроколориметрии используя как критерий разность теплоемкостей, температуру и температурные интервалы перехода разрушения мицелл ГВ.
11. Разработана методика выделения экстрактов и вытяжек из биогумуса, получения препарата гуминового комплекса. Показано положительное влияние гуминового комплекса на иммунную систему с/х растений, что значительно усиливает устойчивость растений к биотическим факторам и повышает урожайность.
12. На основании систематических исследований в полевых и лабораторных условиях выявлена биологическая активность и сортоспецифичность препарата гуминового комплекса, что дает возможность разработки биологически активных фитоиммуномодуляторов.
Предложения по практическому использованию результатов исследований
1. На основе водорастворимой фракции гумусовых соединений, полученных из вермикомпоста на основе червя "Старатель", перспективно создание нового класса иммуномодуляторов, стимуляторов роста и развития растений.
2. Гуминовый комплекс, полученный путем щелочной экстракции из вермикомпостов, может быть рекомендован в качестве компонента питательных сред для культивирования зародышей с целью селекции новых сортов.
Экономическая оценка результатов исследований
Широкое использование в сельскохозяйственном производстве вермикомпостов (биогумуса), несомненно, будет способствовать оздоровлению окружающей среды, снижению применения химических средств защиты растений, повышению урожайности и устойчивости к болезням и вредителей сельскохозяйственных культур и получению экологически безопасной пищевой продукции.
Предварительные расчеты показали, что производство биогумуса, приготовление на его основе раствора, обработка семян, опрыскивание посевов экономически выгодно в связи с повышением урожайности сельскохозяйственных культур и исключением химических средств защиты.
В качестве контрольного варианта была взята технология возделывания гороха без обработки против болезней и вредителей и технология возделывания гороха с использованием предпосевной обработки семян и двукратной внекорневой обработки растений гороха биопрепаратом гуминового комплекса на основе копролитов дождевого червя "Старатель" в концентрации 1,5×10 -4 %. Прибавка к урожайности составила 12,6 ц/га по сравнению с контролем. Валовой сбор основной продукции в контрольном варианте составил 137 т., в опытном - 263т., что дает возможность снижения себестоимости на 1442,1 руб. на 1т. основной продукции (в ценах 2007 года).
Прибыль от внедрения подобной разработки в сельскохозяйственное производство может составить 12323,07 рублей на гектар посевов бобовых культур (в ценах 2007 года).
Из проведенного выше анализа экономической эффективности контроля и исследуемых вариантов можно сделать вывод, что обработка семян и опрыскивание посевов вытяжкой из биогумуса экономически выгодно.
Список работ, опубликованных по теме диссертации
1. Юшкова Е.И., Павловская Н.Е., Даниленко А.Н., Ботуз Н.И., Полозова Е.Ю., Борзенкова Г.А. Физико-химическая характеристика и биологическая активность биогумуса. - Орел: Издательство ОРАНС, 2007. - 140 с. (монография).
2. Юшкова Е.И., Таканаев А.А., Павловская Н.Е., Яроватая М.А. Разработка биологически – активных веществ на базе вермикультуры // Экология и жизнь: Сборник материалов VII Международной научно-практической конференции. – Пенза, 2004. – С. 149-151.
3. Юшкова Е.И., Таканаев А.А., Павловская Н.Е., Яроватая М.А. Выделение и функциональная характеристика некоторых белков и пептидов из Eisenia Fetida // Материалы Второго съезда Общества биотехнологов России. / Под ред. Василова Р.Г. – М.: МАКС Пресс, 2004. – С. 196.
4. *Юшкова Е.И., Павловская Н.Е., Даниленко А.Н., Ботуз Н.И. Физико-химические свойства экстрактов из биогумуса разной степени зрелости. // Сорбционные и хроматографические процессы. – 2006.- т.6.- № 1. – С.70-79.
5. *Юшкова Е.И., Павловская Н.Е., Даниленко А.Н., Ботуз Н.И. Выделение и исследование некоторых физико-химических свойств гиматомелановых кислот методом ВЭЖХ. // Сорбционные и хроматографические процессы. – 2006.- т.6.- № 5. – С. 807-816.
6. *Юшкова Е.И., Павловская Н.Е., Даниленко А.Н., Ботуз Н.И. Сравнительные исследования гуминовых кислот выделенных из компостов и вермикомпостов различного происхождения методом ВЭЖХ. // Сорбционные и хроматографические процессы. – 2006.- т.6.- № 6. – С. 1358-1364.
7. Юшкова Е.И., Яроватая М.А. Выделение и исследование некоторых физико-химических свойств фульвокислот методом ВЭЖХ. // Фундаментальные и прикладные проблемы современной химии в исследованиях молодых ученых: Материалы Международной научной конференции. – Астрахань, 2006. – С. 151-152.
8. Юшкова Е.И. Изучение связывающих и детоксицирующих свойств гуминовых кислот по отношению к различным классам экотоксикантов. // Актуальные проблемы химии и методики ее преподавания: Сборник материалов межрегиональной научно-методической конференции. – Нижний Новгород, 2006. – С. 193-195.
9. Юшкова Е.И. Применение метода ВЭЖХ для определения степени созревания гуминовых веществ в процессе вермикомпостирования. // Аналитика России: Материалы II Всероссийской конференции по аналитической химии с международным участием. – Краснодар, 2007. – С. 68.
10. Юшкова Е.И. Выделение, фракционирование и исследование некоторых физико-химических свойств методом ВЭЖХ гумусовых кислот полученных на основе вермикомпоста. // Хроматография в химическом анализе и физико-химических исследованиях: Всероссийский симпозиум (К юбилею проф. О.Г. Ларионова). – Москва, 2007.- С. 95.
11. Юшкова Е.И. Перспективы использования вермикультуры для утилизации осадков сточных вод. // Инновационные технологии обеспечения безопасности питания и окружающей среды: Материалы Всероссийской научно-практической конференции. – Оренбург, 2007.- С.460-461.
12. Юшкова Е.И., Павловская Н.Е., Даниленко А.Н., Ботуз Н.И. Выделение и сравнительное исследование протеолитической активности экстрактов биогумуса. // Вермикомпостирование и вермикультивирование как основа экологического земледелия в XXI веке: проблемы, перспективы, достижения: Сборник научных трудов международной научно-практической конференции ведущих специалистов, ученых предпринимателей и производственников. - Минск, 2007. - С. 71-72.
13. Юшкова Е.И. Определение средней молекулярной массы белков биогумуса. Актуальные проблемы модернизации химического и естественнонаучного образования: Материалы 55 Всероссийской научно-практической конференции химиков с международным участием. - С-Пб, Изд. РПГУ им. А.И. Герцена, 2008. - С.282-283.
14. *Юшкова Е.И., Даниленко А.Н., Павловская Н.Е., Ботуз Н.И. Исследования методом ВЭЖХ физико-химических свойств фульвокислот компостов и вермикомпостов различного происхождения. // Агрохимия, 2008. - №3. - с. 67-71.
15. Юшкова Е.И. Использование метода 13 С ЯМР-спектроскопии в исследовании гуминовых кислот полученных из вермикомпостов различного срока созревания. // Современные проблемы науки и образования, 2008. - № 6. - С. 134-136.
16. Юшкова Е.И. Зависимость термодинамических свойств разбавленных растворов гуминовых веществ от их относительной степени ароматичности. ГОУ ВПО Орловский государственный университет.- Орел, 2008. Деп. в ВИНИТИ 28.11.08. № 908-В2008.
17. *Даниленко А.Н., Браудо Е.Е., Павловская Н.Е., Юшкова Е.И. Взаимосвязь межу гидрофобностью гуминовых кислот и термодинамическими свойствами их разбавленных растворов. // Биофизика, 2010. - № . – С.
18. Юшкова Е.И. Хроматографическое исследование жирнокислотного состава экстрактов биогумуса. // Экоаналитика – 2009: VII Всероссийская конференция по анализу объектов окружающей среды. - Йошкар-Ола, 2009. – С. 239-240.
19. Юшкова Е.И., Даниленко А.Н. Оптимизация выделения гумусовых кислот методом экстракции. // Экоаналитика – 2009: VII Всероссийская конференция по анализу объектов окружающей среды. - Йошкар-Ола, 2009. – С.240-241.
20. Юшкова Е.И. Химический состав и агрохимическая характеристика биогумуса полученного на основе червя "Старатель". // С-Петербург. Актуальные проблемы модернизации химического и естественнонаучного образования: Материалы 56 Всероссийской научно-практической конференции химиков с международным участием. - С-Пб, Изд. РПГУ им. А.И. Герцена, 2009. - С. 344-345.
21. Юшкова Е.И., Таканаев А.А. Использование целлюлолитических и легнинолитических ферментов вермикультуры для утилизации отходов с/х производства. // Биотехнология. Биомедицинская инженерная и технология современных социальных практик: Сборник трудов Всероссийской научно-практической конференции. – Курск: ГОУ ВПО КГМУ Росздрава, 2009.- С.98-99.
22. Юшкова Е.И., Таканаев А.А. Вермикультура как источник биологически активных соединений для фармакологии и медицины. // Ученые записки Орловского государственного университета. Серия "Естественные, технические и медицинские науки", 2009. - №2 (32). - С.109-112.
23. Юшкова Е.И., Таканаев А.А. Препараты биологической защиты растений на основе вытяжек из биогумуса. - Ученые записки Орловского государственного университета. Серия "Естественные, технические и медицинские науки", 2009. - № 2 (32). - С.112-115.
24. Юшкова Е.И., Павловская Н.Е., Ботуз Н.И.Влияние активного вещества биогумуса на урожай сельскохозяйственных культур. // Организация и регуляция физиолого-биохимических процессов: Межрегиональный сборник научных работ. - Выпуск 11. - ВГУ, 2009. - С. 254-258.
25. Юшкова Е.И., Даниленко А.Н., Павловская Н.Е., Ботуз Н.И.Исследование некоторых физико-химических свойств фульвокислот, выделенных из образцов биогумуса разного времени созревания. // Актуальные проблемы химии и методики ее преподавания. // Материалы Всероссийской научно-практической конференции с международным участием: Нижний Новгород: НПГУ, 2009. - С.177-180.
26. *Юшкова Е.И., Павловская Н.Е. Сравнительное исследование микробиологического состава компостов и вермикомпостов. // Естественные и технические науки, 2010. - № 1. - С.133-135.
27. *Юшкова Е.И., Борзенкова Г.А., Павловская Н.Е., Ботуз Н.И. Испытание активного вещества биогумуса на болезнеустойчивость и урожай гороха. // Хранение и переработка сельхозсырья, 2010. - № .- С.
28. *Юшкова Е.И., Павловская Н.Е., Ботуз Н.И. Влияние биологически активного вещества биогумуса на рост, развитие и урожай картофеля. // Сельскохозяйственная биология, 2010. - № . – С.
29. *Павловская Н.Е., Бородин Д.Б., Юшкова Е.И. Исследование влияния гуминового комплекса вермикомпоста на ферменты антиоксидантной системы гороха. - Агрохимия, 2010. - № 10. – С.
30. *Юшкова Е.И., Павловская Н.Е., Даниленко А.Н. Исследования методом ВЭЖХ физико-химических свойств гуминовых кислот компостов и вермикомпостов разного периода созревания. // Сорбционные и хроматографические процессы, 2010. - № 3. – С. 409-418.
31. Юшкова Е.И., Павловская Н.Е. Получение препарата гуминового комплекса и его влияние на развитие и продуктивность некоторых сельскохозяйственных культур. // Вермикомпостирование и вермикультивирование как основа экологического земледелия в XXI веке: проблемы, перспективы, достижения: Сборник научных трудов 2-ой международной научно-практической конференции ведущих специалистов, ученых предпринимателей и производственников. - Минск, 2010 г.- С. 180-183.
32. *Юшкова Е.И., Павловская Н.Е., Ботуз Н.И. Изучение влияния активного вещества биогумуса на антиоксидантную систему проростков гороха. // Вестник ВГУ. Серия: Химия. Биология. Фармация.- 2010. - № 2. – С.
33. Юшкова Е.И., Даниленко А.Н. Количественное определение гумусовых кислот методом экстракции как показатель степени зрелости вермикомпостов. // Экстракция органических соединений: Материалы IV Международной конференции, Воронеж, 2010 г.
34. Юшкова Е.И., Таканаев А.А. Исследование ферментативной активности некоторых белков и пептидов, выделенных из биомассы дождевого червя Владимирский гибрид "Старатель". // Организация и регуляция физиолого-биохимических процессов: Межрегиональный сборник научных работ. - Выпуск 12. - ВГУ, 2010. - С. .
35. *Юшкова Е.И., Таканаев А.А. Влияние белков и пептидов, выделенных из биомассы дождевого червя Владимирский гибрид "Старатель" на структурную организацию мембран. // Ученые записки Орловского государственного университета. Серия "Естественные, технические и медицинские науки", 2010. - № 2(36).- С.102-106.
* - работы, опубликованные в изданиях, рекомендуемых ВАК (4-6, 14, 17, 26-30, 32, 35).
Выражаю глубокую и искреннюю признательность научному консультанту профессору, д.б.н. Павловской Н.Е., за неоценимый вклад в формировании теоретического фундамента данной тематики; профессору, д.б.н. Таканаеву А.А. за участие в обсуждении и рецензировании глав диссертации; ст. научному сотруднику института биохимической физики РАН им. Н.М. Эммануэля Даниленко А.Н. за помощь в проведении экспериментальных исследований химического состава биогумуса; к.с.х.н. Ботуз Н.И. за сотрудничество и помощь в работе; к.с.х.н., зав. лабораторией иммунитета и защиты растений ГНУ ВНИИЗБК Борзенковой Г.А. за помощь в проведении полевых исследований.